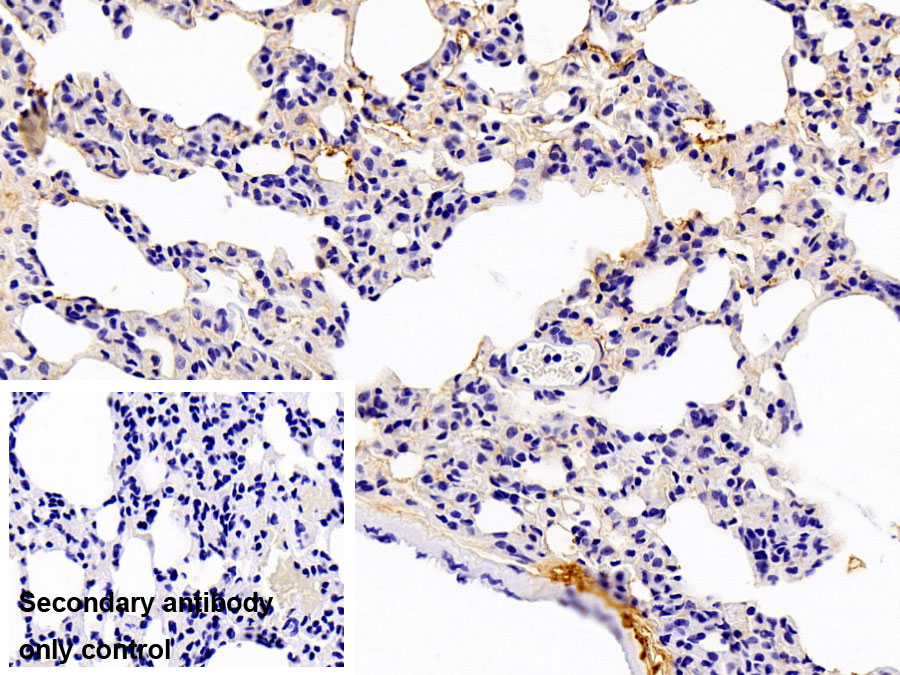

免疫球蛋白A(IgA)多克隆抗体
Polyclonal Antibody to Immunoglobulin A (IgA)
- 编号PAA546Hu01
- 物种Homo sapiens (Human,人)相同的名称,不同的物种。
- 来源多抗制备
- 宿主兔
- 效价-
- Ig类型IgG
- 纯化方式抗原特异性亲和纯化
- 标记物无标记物
- 免疫原NPA546Hu01-免疫球蛋白A(IgA)天然蛋白
- 缓冲液成份磷酸盐缓冲液(pH7.4,含有0.02% NaN3和50%甘油)
- 性状液体
- 浓度500µg/mL
- 且适物种Rattus norvegicus (Rat,大鼠)
- 应用IHC
如果抗体需用于流式细胞术,请参见流式抗体。 - 下载英文说明书 中文说明书
- 规格20µl100µl200µl1ml10ml
- 价格¥ 504¥ 1176¥ 1680¥ 4200¥ 16800
- 欲了解实际交易价格和更多情况,请与当地经销商联系!
特异性
该抗体是针对IgA的兔多克隆抗体。在免疫组织化学染色和免疫印迹实验中能识别IgA。
用法
Western blotting: 0.5-2µg/mL;
Immunohistochemistry: 5-20µg/mL;
Immunocytochemistry: 5-20µg/mL;
Optimal working dilutions must be determined by end user.
储存
经常使用则4°C保存。-20°C保存不超过两年。避免反复冻融。
稳定性
热稳定性以损失率显示。损失率是由加速降解试验决定,具体方法如下:在37°C孵育48小时,没有显著的降解或者沉淀产生。保质期内,在适当的条件下存储,损失率低于5%。
赠品
相关产品
| 编号 | 适用物种:Homo sapiens (Human,人) | 应用(仅供研究使用,不用于临床诊断!) |
| NPA546Hu01 | 免疫球蛋白A(IgA)天然蛋白 | Positive Control; Immunogen; SDS-PAGE; WB. |
| PAA546Hu05 | 免疫球蛋白A(IgA)多克隆抗体 | WB; IHC |
| PAA546Hu01 | 免疫球蛋白A(IgA)多克隆抗体 | IHC |
| SAA546Hu09 | 兔抗人IgA多克隆抗体(辣根过氧化物酶标记) | ELISA; WB; IHC; ICC. |
| LAA546Hu71 | 免疫球蛋白A(IgA)多克隆抗体(生物素标记) | WB; IHC; ICC. |
| SEA546Hu | 免疫球蛋白A(IgA)检测试剂盒(酶联免疫吸附试验法) | Enzyme-linked immunosorbent assay for Antigen Detection. |
| MEA546Hu | 免疫球蛋白A(IgA)检测试剂盒(酶联免疫吸附试验法,小样本) | Enzyme-linked immunosorbent assay for Antigen Detection. |
| AEA546Hu | 抗免疫球蛋白A抗体(Anti-IgA)检测试剂盒(酶联免疫吸附试验法) | Enzyme-linked immunosorbent assay for Antibody Detection. |
| SCA546Hu | 免疫球蛋白A(IgA)检测试剂盒(化学发光免疫分析法) | Chemiluminescent immunoassay for Antigen Detection. |
| LMA546Hu | 免疫球蛋白A(IgA)等多因子检测试剂盒(流式荧光发光法) | FLIA Kit for Antigen Detection. |
| KSA546Hu01 | 免疫球蛋白A(IgA)检测试剂盒DIY材料(酶联免疫吸附试验法) | 自己动手制作ELISA试剂盒的主要材料 |
参考文献
| 杂志 | 参考文献 |
| IDOSI Publications | Sequence-Based Typing-Study on the Relationship Between Subclinical Mastitis and BoLA-DRB3.2* Allelic Polymorphism in Egyptian Cows[Idosi: Source] |
| international Journal of food and nutritional sciences | EVALUATION OF PHYSICO-CHEMICAL PROPERTIES OF COLOSTRUM SUPPLEMENTED DAHI[Ijfans: Source] |
| Poultry Science | Effects of Clostridium butyricum on growth performance, immune function, and cecal microflora in broiler chickens challenged with Escherichia coli K88[Pubmed: 24570422 ] |
| Clinical and Vaccine Immunology | Specific humoral immune response induced by Propionibacterium acnes can prevent Actinobacillus pleuropneumoniae infection in mice[Asm: Source] |
| Clin Vaccine Immunol. | Speci?c Humoral Immune Response Induced by Propionibacterium acnes Can Prevent Actinobacillus pleuropneumoniae Infection in Mice[Pubmed:24429068] |
| Journal of Proteomics | Proteomics on porcine haptoglobin and IgG/IgA show protein species distribution and glycosylation pattern to remain similar in PCV2-SD infection[Pubmed:24576640] |
| Food & Function | Dietary squid ink polysaccharide could enhance SIgA secretion in chemotherapeutic mice[Pubmed:25308407] |
| Pediatrics | Oropharyngeal colostrum administration in extremely premature infants: an RCT.[Pubmed:25624376] |
| Front Microbiol | Fecal microbiota transplantation and bacterial consortium transplantation have comparable effects on the re-establishment of mucosal barrier function in mice with intestinal dysbiosis[PubMed: 26217323] |
| Food and Agricultural Immunology | Effects of fermented cottonseed meal on growth performance, serum biochemical parameters, immune functions, antioxidative abilities, and cecal microflora in broilers[10.108:09540105.2017.1311308 ] |
| SYSTEMISCHE ENTZÜNDUNG BEI CHRONISCHER NIERENINSUFFIZIENZ – DIE ROLLE DER DARMFLORA[patent:US9763998B2] | |
| Water Research | Sub-chronic inhalation of reclaimed water-induced fibrotic lesion in a mouse model[Pubmed:29655095] |
| Vaccine | Recombinant Lactococcus lactis co-expressing OmpH of an M cell-targeting ligand and IBDV-VP2 protein provide immunological protection in chickens[Pubmed:29289381] |
| Food and Agricultural Immunology | Effects of and on growth performance, immune function and volatile fatty acid level of caecal digesta in broilers[10.1080:09540105.2018.1457013] |
| Probiotics Antimicrob Proteins | Effect of Multi-Microbial Probiotic Formulation Bokashi on Pro-and Anti-Inflammatory Cytokines Profile in the Serum, Colostrum and Milk of Sows, and in a …[Pubmed:29305686] |
| SAGE Open Medicine | Altered immunoglobulins (A and G) in Ghanaian patients with type 2 diabetes[Pubmed:29623201] |
| Nephrology Dialysis Transplantation | The gut flora modulates intestinal barrier integrity but not progression of chronic kidney disease in hyperoxaluria-related nephrocalcinosis[Pubmed: 31081025] |
| Current Developments in Nutrition | Yacon (Smallanthus sonchifolius): Effect on Integrity of Intestinal Barrier, Inflammatory Response and Oxidative Stress in Animal Model of Colon Cancer (P06-052-19)[Pubmed: 31225040] |
| Nutrients. | Effects of Paramylon Extracted from Euglena gracilis EOD-1 on Parameters Related to Metabolic Syndrome in Diet-Induced Obese Mice[Pubmed: 31330894] |
| International Journal of Biological Macromolecules | Effects of polysaccharides from Yingshan Yunwu tea on meat quality, immune status and intestinal microflora in chickens[Pubmed: 32224178] |
| Effect Long-Term Exposure to Different Doses of Lipopolysaccharides on the Intestinal Mucosal Immune Barrier[] | |
| Italian Journal of Animal Science | Effects of chitooligosaccharide supplementation on laying performance, egg quality, blood biochemistry, antioxidant capacity and immunity of laying hens during the …[] |
| 博士论文 | Women Scientist Scientist Mentor[] |
| Acta Paediatr | MicroRNA profiling in Chinese children with Henoch©\Schonlein purpura and association between selected microRNAs and inflammatory biomarkers[33533510] |
| Environ Pollut | Trace endotoxin in reclaimed water is only one of the risk sources in subchronic inhalation exposure[34090073] |
| J Ethnopharmacol | Monascus ruber fermented Panax ginseng ameliorates lipid metabolism disorders and modulate gut microbiota in rats fed a high-fat diet[34098018] |
| Microbiology Spectrum | Dietary Supplementation of Inulin Ameliorates Subclinical Mastitis via Regulation of Rumen Microbial Community and Metabolites in Dairy Cows[34494854] |
| Food Research International | Sulfated modification enhances the immunomodulatory effect of Cyclocarya paliurus polysaccharide on cyclophosphamide-induced immunosuppressed mice through …[34865774] |
| Food Funct | Three Urban of China: A Cohort Study of Maternal-Infant Factors and HM Protein Components[Pubmed:35438093] |
| Food and Agricultural Immunology | The effect of the multi-strain probiotic preparation EM Bokashi® on selected parameters of the cellular immune response in pigs[] |
| Journal of Functional Foods | Bovine lactoferricin ameliorates intestinal inflammation and mucosal barrier lesions in colitis through NF-κB/NLRP3 signaling pathways[] |
| Journal of Dentistr Journal of Dentistry Indonesia | Salivary IgA Depression in Drug-Influenced Gingival Enlargement among Hypertensive Patients[] |